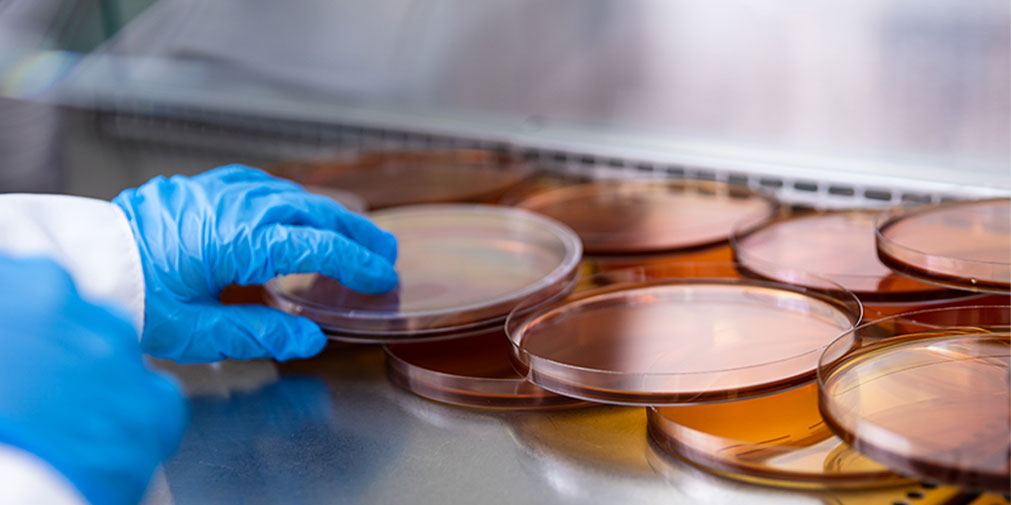

Uma das maiores
estruturas laboratoriais
do Brasil

O Freitag Laboratórios
Um pouco da
nossa história
Saiba mais sobre a jornada do laboratório
O Freitag nasceu através de uma fusão entre o Laboratório Weingärtner (1956) e o Laboratório Freitag (1978). Em 2002, surge o Laboratório Freitag & Weingärtner, focado em análises clínicas humanas.
A fusão de dois laboratórios renomados permitiu a expansão da empresa, que conquistou abrangência regional e estadual. O laboratório focou em atendimentos corporativos, impulsionando a criação de novos serviços e divisões para atender as empresas.
Em 2006 iniciou a Divisão Ambiental e de Alimentos. Em 2008 surgiu a Divisão Veterinária. Já em 2009 a Divisão Ambiental e de Alimentos ganhou autonomia e foi denominada como Freitag Laboratórios, ganhando um novo espaço para as atividades e permitindo investimentos para ampliar o escopo de trabalho e conquistar diversos credenciamentos.
Em 2019, o Freitag Laboratórios mudou-se para a sede própria no Distrito Industrial de Timbó (SC). Com uma área de 5.400 m² e 2.400 m² de área construída, o laboratório passou a ser uma das maiores estruturas laboratoriais do Brasil.
Em 2022 o laboratório está se preparando para uma expansão em sua sede permitindo o aumento de sua capacidade produtiva e a implantação de novos métodos. Estamos sempre pavimentando a estrada do nosso futuro.
Confira nossos conteúdos no YouTube, clique aqui.
Qualidade é tudo, confiabilidade é o nosso resultado
- Escopo de ensaios acreditado e diversificado
- Acessibilidade no laboratório e relacionamento com clientes para debater resultados
- Grande valor agregado ao serviço
- Suporte técnico
- Comprometimento com prazos e resultados
- Estrutura laboratorial de 2.400 m²
- Treinamentos gratuitos para clientes
Acesse nossa política de qualidade
Política de QualidadeMissão
Realizar serviços de excelência que gerem qualidade de vida.
Visão
Ser um laboratório de referência no Brasil.
Valores
Comprometimento, excelência, qualidade e valorização do cliente. Agilidade, trabalho em rede de parcerias, verdade e transparência.

A melhor estrutura
Complexo laboratorial com recursos e equipamentos de tecnologia avançada.

Parcerias de sucesso
Parcerias sólidas com a comunidade científica para desenvolvimento tecnológico e inovação.

Profissionais com expertise
Especialistas altamente capacitados e qualificados para cada área de atuação.
Trabalhe com o Freitag
Desenvolva sua jornada profissional em um dos melhores laboratórios do país, com um time que evolui constantemente!
Trabalhe conosco















